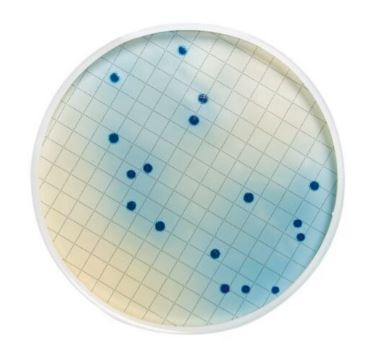
Rosolic Acid (Dehydrated)

Description
Selective agent to be added to mFC broth medium
Application
Selective agent to be added to mFC broth medium
Type of Test
BioburdenMicrobial Limits
BioburdenMicrobial Limits
Packaging
Dehydrated 25 g in plastic bottle
Specifications
Incubation Time: 24 hrs ± 2
Culture Medium
Rosolic Acid
Analysis Note
Target Microorganisms: Rinse Buffers and Additives
PROPERTIES
form
powder (dehydrated)
shelf life
12 mo.
packaging
pkg of 25 g
color
yellow to red
input
sample type bottled water
sample type soft drink
sample type cosmetics
sample type sport drink
sample type cider
sample type wine
sample type food(s)
sample type beverage(s)
sample type beer
pH
6.8±8.2 (25.0 °C)
application(s)
clinical
cosmetics
environmental
food and beverages
industrial qc
microbiology
water monitoring
compatibility
for use with MF-method
for use with Microfil®
for use with MicropreSure®
for use with Milliflex®
shipped in
ambient
storage temp.
2-30°C
Legal Information
MICROFIL is a registered trademark of Merck KGaA, Darmstadt, Germany
MICROPRESURE is a registered trademark of Merck KGaA, Darmstadt, Germany
MILLIFLEX is a registered trademark of Merck KGaA, Darmstadt, Germany

![OGYE selective supplement [Pack of 10 vials]](https://idealmedical.co.za/wp/wp-content/uploads/2022/08/553-ogye-selective-supplement-300x300.jpg)
![Clostridium perfringens selective supplement [Pack of 10 vials]](https://idealmedical.co.za/wp/wp-content/uploads/2022/09/590-tsc-agar-supplement-300x300.jpg)

Reviews
There are no reviews yet.